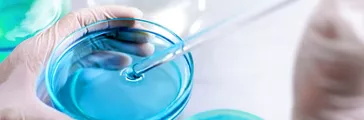
Hands performing experiment with chemicals in laboratory

Sustainability Science
支持客户轻松识别和选择具有特定可持续性属性的产品的能力。

Sustainability Science 在我们的市场中
帮助客户实现其可持续发展目标
从减排到循环经济,再到重视水和自然环境——这六个支柱品牌代表了我们产品组合的可持续性属性,让您更轻松地发现、比较,并为我们共同的世界创建更具可持续性的解决方案。我们的产品可持续性声明依赖于技术知识和证据,并酌情使用公认的国际标准和认证系统,从生命周期的角度做出。因此,您可以信任您从陶氏购买的材料将带来他们承诺的可持续发展效益。 要了解更多,请观看此短片。 点击此处,了解有关可持续发展的这些化学构成部分的更多信息。
注册以在您的收件箱中接收更多此类内容。
Decarbia™
加速脱碳
我们正在实施和推进技术,以制造排放量更低的 GHG 产品。这反过来又帮助我们的客户减少他们的GHG排放,因为我们合作实现价值链脱碳,一直到消费者。
相关应用

楼房、建筑和基础设施
通过与建筑师、工程师、建筑设计师、承包商和制造商合作,我们正在开发在整个建筑环境中增强性能、耐用性、美观性和可持续性的解决方案。

冷链绝缘
提供轻巧、节能的冷链和保温解决方案,帮助满足全球对健康和新鲜食品的需求。

冷屋顶涂料
提供具有耐用性能和长期热性能能效的弹性屋顶涂料。

再生能源
用可再生能源技术解决工业挑战,从保护光伏电池的聚烯烃和硅基溶液,到用于聚光太阳能和地热系统的热传导液。
气候周合作

脱碳价值链 – 现在

Jim Fitterling 讨论了陶氏的脱碳过程

C2ES 活动摘要 – 第 1 部分

C2ES 活动摘要 – 第 3 部分

陶氏和碳足迹总账
用于脱碳的额外资源

零排放路径:陶氏每年投资约 10 亿美元,以推动我们制造资产的增长和脱碳。

碳中性外立面: 客户可申请项目专属的碳中和证书。

乙烯丙烯二烯三元共聚物 (EPDM): 通过更具可持续性的解决方案,推动实现更好的橡胶球。

陶氏聚氨酯工厂的三项 ISCC PLUS 认证加强了化石原料替代的进程。

陶氏的 MobilityScience™ 解决方案支持弹性低碳交通。
Ecolibrium™
生物基材料
这些产品将生物量原料作为原始化石原料的替代产品,无论需求是投运还是新配方,都能提供同等的性能。凭借直接来源和质量平衡解决方案,我们正在与客户密切合作,推进生物基解决方案。
相关应用

运动休闲鞋
结合生物聚合物,在可持续性和有效性能之间取得平衡,以此对鞋类设计采取新方法。

建筑内墙涂料
使用自然成分,在降低油漆和涂料碳足迹的同时,提供优质的油漆性能。

包装
通过使用生物原料制造的产品实现生物包装,这些原料来自本来浪费的资源,如玉米炉。

家庭护理及工业-公共设施清洗
为家庭护理、工业和公共机构市场提供天然的清洁配方。

个人护理的可持续性
提供广泛的生物衍生个人护理成分,以提高可持续发展和性能。
特色品牌

ENGAGE™ REN
ENGAGE™ REN 提供由生物圈原料制成的高性能聚烯烃弹性体 (POE),通过 ISCC + 质量平衡系统认证。通过利用可再生和废物源材料(如废食油),它有助于减少对原始化石原料的依赖,并支持循环经济。

NORDEL™ REN
NORDEL™ REN 是一款基于生物的 EPDM 橡胶,专为汽车、基础设施和消费者应用而设计。它使用非食品生物残余物,经过 ISCC PLUS 质量平衡认证,在降低碳足迹和支持脱碳的同时实现与原始材料相当的性能。

AFFINITY™ RE
AFFINITY™ RE 提供专为热熔粘合剂和包装用途定制的生物基聚烯烃弹性体。它由高油(可持续管理森林的副产品)等原料制成,经过 ISCC 质量平衡认证,有助于减少粘合剂和包装系统的碳足迹。
用于生物衍生解决方案的额外资源

ENGAGE™ REN 聚烯烃弹性体采用可再生能源和植物基原材料生产,使鞋类更具可持续性。

涂料生物基技术: 提供生物基丙烯酸乳液,实现卓越的油漆性能。
陶氏和 Tito Pabón 将植物变成油漆,以提供高性能、可持续的涂料。

质量平衡有助于消费者以最具成本效益的方式获得生物产品。

AFFINITY™ RE 将低碳足迹与高性能和高品质饰面相结合,可为包装提供增强的可持续特性,使其脱颖而出。

在陶氏,我们走在可持续创新的最前沿,在北美推出全新的 Renuva™ 和 Ecolibrium™ 丙二醇解决方案。
Renuva™
回收材料
我们通过投资于机械、化学和其他高级回收工艺,满足对回收材料日益增长的需求。通过将废物流转化为新的原材料,作为化石原料的替代品,我们帮助客户实现其回收含量目标。
相关应用

消费品
提供外观、功能、生产力和更低成本与性能、可靠性和可持续性的正确组合。

软包装
使用消费后回收塑料增强柔性包装——在储存和运输中保护货物的同时提供高性能。陶氏的先进材料有助于在不影响质量或耐用性的情况下最大限度地提高回收利用量。

汽车内饰
陶氏的先进内饰材料专为循环发展而设计——采用高性能组件和回收树脂系统,以提高舒适度、降低重量并能够重复使用报废汽车材料。

化妆品包装
使用由混合塑料废物制成的圆形原料制造的材料,生产出惊艳、高质量的化妆品包装。这是通过先进的回收技术实现的。

人造草坪
使用富含消费后回收塑料的产品设计您的高性能草坪。

床垫回收计划
通过床垫回收计划实现聚氨酯的低碳和循环未来。
特色品牌

ENGAGE™ CIR
ENGAGE™ CIR 提供专为循环设计的高性能聚烯烃弹性体——通过质量平衡系统将回收原料融入其中。它支持降低对原始化石材料的依赖,同时保持耐用性、灵活性和加工的便利性。

AMPLIFY™ Si
AMPLIFY™ Si 能够更好地利用回收塑料和填料,支持循环经济设计,同时在木质塑料复合材料和其他应用中保持强度和性能。
循环利用解决方案的额外资源

使用回收材料打造耐用、有吸引力且具可持续性的平台。AMPLIFY™ Si 有助于降低能源成本和碳足迹。

通过先进/化学回收计划的化学回收进行跨价值链协作,为旧床垫赋予新的生命。

材料生态系统正在释放废物的价值。我们正采取系统方法,以使其更加强大。

Renuva™ 项目由陶氏开发,旨在协作将废物转化为原材料。

在陶氏,我们走在可持续创新的最前沿,在北美推出全新的 Renuva™ 和 Ecolibrium™ 丙二醇解决方案。
Circulibrium™
循环设计
我们制造的材料可以更高效地使用,并支持循环经济的应用,这些应用旨在回收、回收并反馈到价值链中。这有助于我们的客户实现循环,减少填埋量,同时为下一代创造价值。
探索我们的 Circibrium™ 案例研究库

材料 生态系统:第 1 章
注重生态的消费者:购买力如何推动系统变化。

材料 生态系统:第 2 章
从设计开始:循环“通过设计”如何加速。

材料 生态系统:第 3 章
在废料中发现价值:废弃物收集和循环利用方面取得进展的迹象。

材料 生态系统:第 4 章
材料来源:创新回收技术如何将更多塑料转化为高价值废弃物。

纸杯挑战
陶氏的 RHOBARR™ 320 阻隔分散剂能够从纸杯中回收高达 99% 的纤维,支持循环经济目标。通过减少浪费、提高可回收性以及降低水和材料用量,陶氏为制造商、消费者和地球提供可持续的解决方案。
特色品牌

INFINAIR™
用于循环技术的 INFINAIR™ 聚合物采用循环设计——机械可回收,具有 90% 以上的开环结构和热塑性,可在新应用中重复使用。

VORAMER™
VORAMER™ 聚氨酯粘合剂系统专为支持环状而设计,是重新粘合泡沫、橡胶和木材等碎纸材料的理想材料。VORAMER™ 通过实现报废内容的再利用,帮助减少浪费并延长材料寿命。
循环解决方案的额外资源

通过跨价值链协作,我们证明进行高质量的阻隔袋到袋回收是可能的。

VORAMER™ 聚氨酯粘合剂适用于多种应用,包括操场表面和跑道。

推出循环解决方案和可持续创新,我们很高兴能与合作伙伴合作,共同打造更加绿色的材料科学未来。
Returna™
生物降解性
这些可生物降解的材料分解为天然存在的物质,以减少人类活动对生态系统的影响。我们的方法结合了创新优势和最佳技术实践,使我们的客户能够在保持性能的同时利用可生物降解的材料。
探索我们的 Retura™ 案例研究库

UCON™ Trident™ 32 AW 液压油成功
1995 年,德克萨斯州市的驳船码头液压起重机从 ISO 32 矿物油转换到 UCON 三叉戟32 AW 液压油,以解决环境问题。从那时起,它就一直运行,没有问题,消除了油的光泽,表现出出色的性能,从而进一步实现转换。

UCON 润滑剂清洁气体储存形成改善流动性
墨西哥湾沿岸的气体储存设施从矿物油润滑剂换到 UCON 压缩机润滑剂 R-1,减少了井下积垢和污泥形成。这一变化使得化学处理需求不再重要,每年节省 150,000 美元,压缩机可靠性和流速也提高了 10-15%。
用于生物降解解决方案的额外资源

ECOllaboration概念集合,激发对美容成分和包装的整体循环方法。

SunSpheres™ 生物基防晒增效剂: 一种生物衍生且易于生物降解的 SPF 增强剂解决方案,可在防晒护理中实现更高的 SPF 效率。

创新表面活性剂: 一组创新的非离子、阴离子和低泡表面活性剂产品组合,可以降低我们对环境的影响。

MaizeCare™ 工具箱: 发掘 MaizeCare™ 的配方,这是一种来源于玉米的生物基聚合物,可在护发造型方面提供灵活性。
Resoursa™
资源效率
我们设计的材料能够帮助客户提高效率,减少重要资源的使用,如水和能源在他们的流程中的使用。我们与合作伙伴合作,致力于减少产品使用阶段排放,同时提高优化制造的门槛。
探索我们的 Resoursa™ 案例研究库

通过更好的食品包装减少温室气体排放。
陶氏和 AEON 的真空皮肤包装 (VSP) 通过减少食物浪费和延长保质期,减少食品活动的 GHG 排放量,应对气候变化,后者占全球排放量的 28-35%。VSP 增强了日本的可持续性和消费者接纳度。

陶氏 SSG 技术:50 年玻璃幕墙创新
陶氏的有机硅结构玻璃装配 (SSG) 技术革新了玻璃幕墙,确保了 50 多年的耐用性和能源效率。其久经考验的性能继续推动时尚的建筑设计,同时满足全球最高安全与可持续发展标准。
用于资源利用效率解决方案的额外资源

用于洗衣剂的有机硅泡沫控制: 了解洗衣剂的浓缩配方为何具有巨大优势。

DOWSIL™ 8016 水性树脂: 水性有机硅树脂,100% 无溶剂。

使用 DOWSIL™ 浸入式冷却技术将云浸入可持续发展中。

为电信导管和微导管应用建立更强大的连接。
我们致力于将您与相关专家和资源对接以应对任何挑战。


















